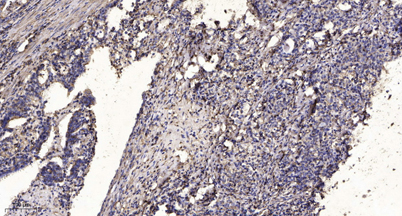

Rab11-FIP4 rabbit pAb
 One-click to copy product information
One-click to copy product information$148.00/50µL $248.00/100µL
| 50 µL | $148.00 |
| 100 µL | $248.00 |
Overview
| Product name: | Rab11-FIP4 rabbit pAb |
| Reactivity: | Human;Mouse |
| Alternative Names: | RAB11FIP4; ARFO2; KIAA1821; Rab11 family-interacting protein 4; FIP4-Rab11; Rab11-FIP4; Arfophilin-2 |
| Source: | Rabbit |
| Dilutions: | Western Blot: 1/500 - 1/2000. Immunohistochemistry: 1/100 - 1/300. ELISA: 1/40000. Not yet tested in other applications. |
| Immunogen: | The antiserum was produced against synthesized peptide derived from human RAB11FIP4. AA range:452-501 |
| Storage: | -20°C/1 year |
| Clonality: | Polyclonal |
| Isotype: | IgG |
| Concentration: | 1 mg/ml |
| Observed Band: | 95kD |
| GeneID: | 84440 |
| Human Swiss-Prot No: | Q86YS3 |
| Cellular localization: | Endosome . Cytoplasm, cytoskeleton, spindle . Cytoplasm, cytoskeleton, microtubule organizing center, centrosome . Recycling endosome membrane ; Peripheral membrane protein. Cleavage furrow . Midbody . Cytoplasmic vesicle . Recruited to the cleavage furrow and the midbody during cytokinesis. . |
| Background: | Proteins of the large Rab GTPase family (see RAB1A; MIM 179508) have regulatory roles in the formation, targeting, and fusion of intracellular transport vesicles. RAB11FIP4 is one of many proteins that interact with and regulate Rab GTPases (Hales et al., 2001 [PubMed 11495908]).[supplied by OMIM, Apr 2008], |
-
 Western Blot analysis of various cells using Rab11-FIP4 Polyclonal Antibody
Western Blot analysis of various cells using Rab11-FIP4 Polyclonal Antibody -
 Western blot analysis of lysates from 293, COLO, HUVEC, HepG2, and HT-29 cells, using RAB11FIP4 Antibody. The lane on the right is blocked with the synthesized peptide.
Western blot analysis of lysates from 293, COLO, HUVEC, HepG2, and HT-29 cells, using RAB11FIP4 Antibody. The lane on the right is blocked with the synthesized peptide. -
Immunohistochemical analysis of paraffin-embedded human Gastric adenocarcinoma. 1, Antibody was diluted at 1:200(4° overnight). 2, Tris-EDTA,pH9.0 was used for antigen retrieval. 3,Secondary antibody was diluted at 1:200(room temperature, 45min).
Immunohistochemical analysis of paraffin-embedded human Gastric adenocarcinoma. 1, Antibody was diluted at 1:200(4° overnight). 2, Tris-EDTA,pH9.0 was used for antigen retrieval. 3,Secondary antibody was diluted at 1:200(room temperature, 45min).

 Manual
Manual